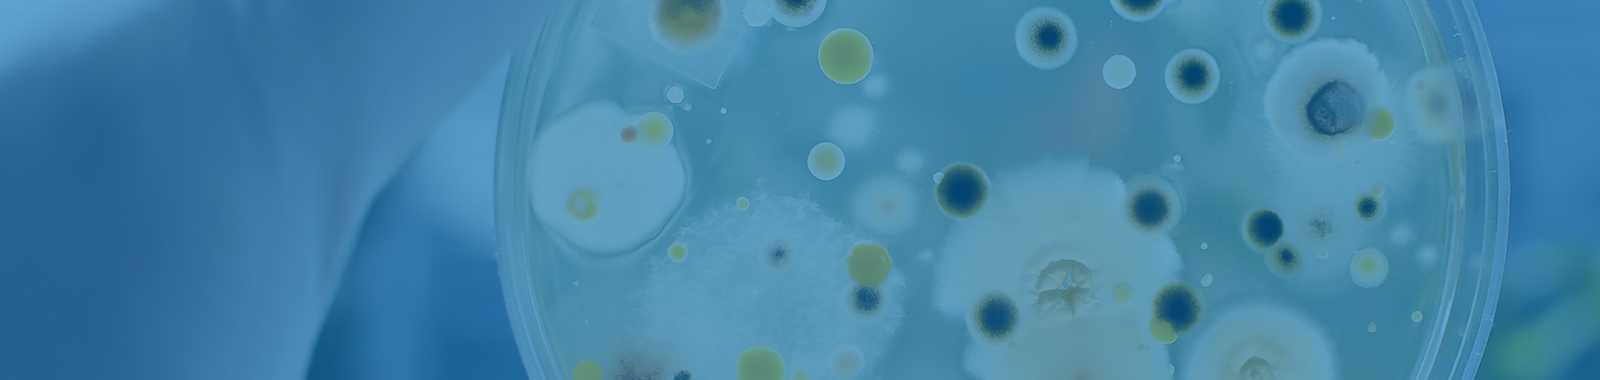
Bacteria & Co for the Bewildered; ‘a Beginners’  Guide to Food Microbiology’

Search >>
Bacteria & Co for the Bewildered; ‘a Beginners’ Guide to Food Microbiology’
Contact us- What microorganisms are
- Effects of microorganisms experienced in daily life - examples
- Diversity of microorganisms and their environments
- About the names of microorganisms
- Significance of microorganisms in foods
- Sizes, units, and numbers
- Multiplication, survival and death
- Movement and cross-contamination in food handling
- Jargon-busting; terms and definitions
- Food production examples
- Food spoilage examples
- Food poisoning examples
- Other significant microbiology in food facilities
- Controls in food processing
- Cleaning and disinfection
- Hygienic equipment
- What happens to samples in a microbiological testing laboratory
- How to read a microbiological results certificate
- The legal bit – food safety and food hygiene
- Food industry professionals and others who have no background in microbiology, or who may have only basic food safety knowledge
- Food Production roles
- Engineers
- Maintenance Technicians
- Newcomers to Quality and Technical Functions
- Beginners’ guide
- Jargon demystified
- Certificates of Analysis explained
- Understand how microorganisms affect food and food manufacturing
- Opportunities to ask our expert questions
No previous knowledge required
Ali Aitchison | Senior Food Safety Consultant | Eurofins Food Testing UK Ltd.